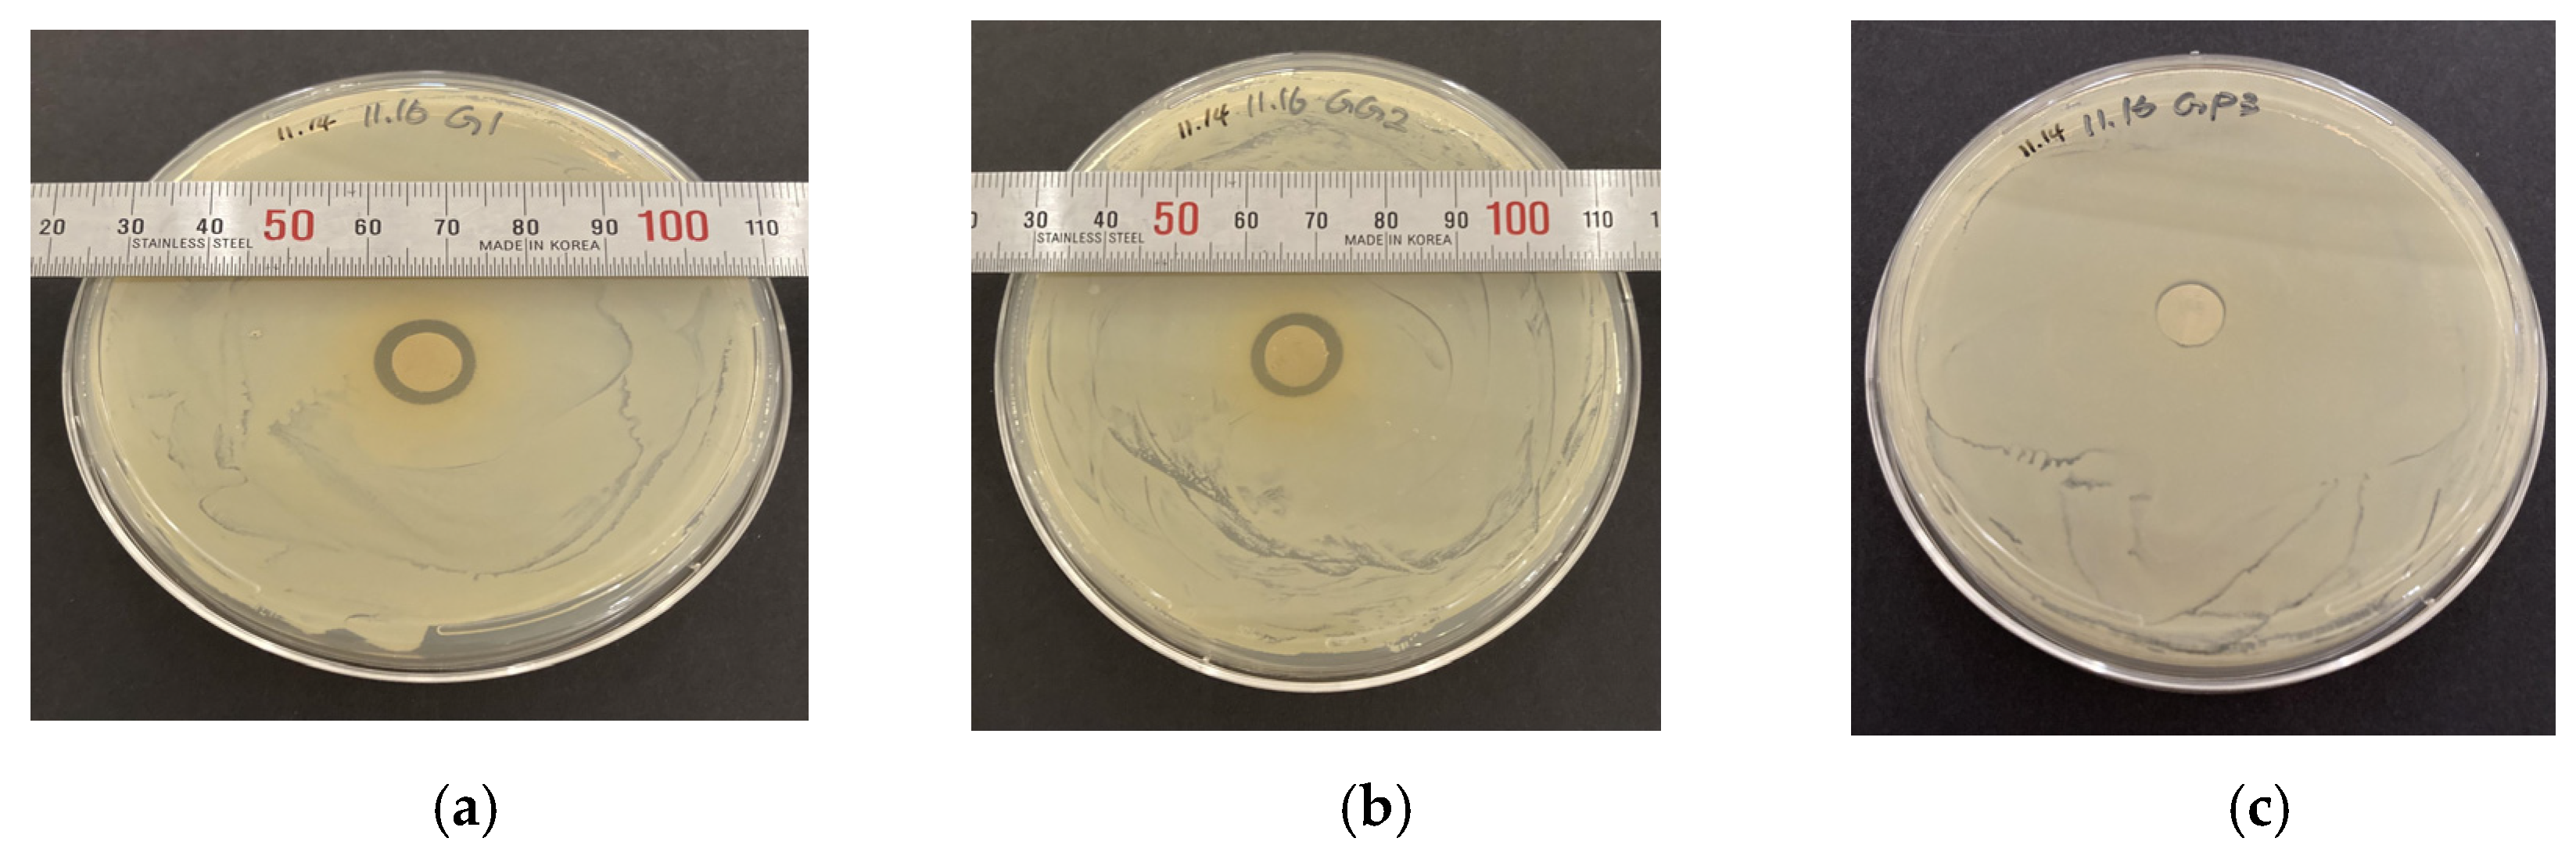
Processes 10 00512 g010a 550

1. Introduction
Diabetics have high levels of reactive oxygen species (ROS) and not enough antioxidants to neutralize them [
1]. Diabetics also have low levels of intracellular glutathione [
2]. Enzymatic glutathione redox systems, such as glutathione (GSH), glutathione reductase (GR), and glutathione peroxidase (Gpx), can neutralize excess ROS and maintain a proper cellular environment [
3]. Free radicals are formed disproportionately in diabetes; abnormally high levels of free radicals and the simultaneous decline of antioxidant defense mechanisms can lead to the development of insulin resistance [
4]. These consequences of oxidative stress can promote the development of complications such as diabetes mellitus [
5]. Concerning diabetes, antioxidant supplementation has shown benefits and is currently available in the market as oral medicine. GSH antioxidant therapy could alleviate the increased oxidative stress and emerge as an additional therapeutic modality as inflammation leads to insulin resistance and Type 2 diabetes [
6]. Diabetic body organs have high levels of oxidative stress, which means too much free ROS and not enough antioxidants to neutralize them [
1]. Oxidative stress plays a major role in the pathogenesis of bone in both types of diabetes mellitus. Researchers found that ROS participates in bone remodeling, with direct involvement of osteoclast-generated superoxide and bone degradation [
7]. The enzymatic glutathione redox system has emerged as a supplementary therapeutic drug for diabetics to alleviate the increased presence of oxidative stress and inflammation. Several in vitro and animal studies have shown that oxidative stress diminishes bone formation by reducing the differentiation and survival of osteoblasts [
8]. Clinical studies have also suggested that the involvement of antioxidants plays a role in the pathogenesis of bone and muscle loss [
9]. However, according to the author’s knowledge, a dermal antioxidant delivery mechanism for diabetic patients has not been explored yet. The goal of this study is to develop a mechanism for the delivery of GSH through a skin patch on a diabetic body.
Over the past three decades, there have been advances in skin regeneration using tissue engineering approaches [
10]. However, there is no antibacterial bandage available in the market that is particularly suitable for a patient with diabetes. Diabetic patients are prone to microbial-induced inflammation due to diseases or skin injuries. Diabetic skin ulcers are not only painful diseases but also potentially life-altering and even fatal medical conditions. According to a study in the journal Diabetes Care, of the 29.1 million Americans who live with diabetes, 15 percent will eventually develop ulcers. Eighty-four percent of all lower-limb amputations are preceded by ulcers. Clinicians are continually exploring new ways to combat this condition better. A combination of surgical and antibiotic treatment is mandatory in virtually all wound infections [
11]. Local drug delivery can attain a concentration of more than a hundredfold higher for the drugs in surgical grafting or infection sites compared to a systemic drug regimen [
12]. GSH, in addition to being the most potent antioxidant, is also a powerful anti-inflammatory agent [
13]. Immobilizing glutathione with a skin graft or bandage via a nanofiber mesh can maintain skin regeneration and control microbial-induced inflammation [
14]. Drugs can also be released at the implant site long enough to maintain the proper tissue function around the implant without causing any side effects [
15]. We have developed an electrospun nanofiber membrane NFM that can be used as a drug delivery system. The goal of this study was to develop a method to attach GSH with PCL NFM and determine whether the produced fiber mesh can be used as a transdermal anti-oxidative drug delivery system. The mechanism of attaching nanofiber with drugs (infection resistant) will prevent the growth of bacteria. GSH, a powerful antioxidant naturally produced in the body, is a small tripeptide molecule composed of three amino acids: glutamic acid, cysteine, and glycine. The antioxidant activity of GSH is well established in various research. GLU is a clear liquid that is primarily used for the sterilization of medical equipment. It has a highly reactive chemical characteristic and antibacterial activity. The attachment of drugs (GSH-GLU) to the PCL nanofiber is a mechanism that this study is pursuing in which the drug would release gradually and steadily. This also is considered the novelty of our study by having a skin equivalent or wound healing model for diabetic patients that not only targets the antibacterial properties but the antioxidant purposes. The released GSH will prevent inflammation and any other undesired effect that might lead to the progression of the disease or in worst cases, surgeries such as amputation. This, in turn, would not only be cost-effective but also reduce the healing time of wounds.
2. Materials and Methods
2.1. Materials
This study used poly (ε-caprolactone) beads (pellet size~3 mm, average Mn 80,000) and acetone (laboratory reagent ≥ 99.5%) to prepare the PCL fibers. The set up is shown in
Figure 1a which demonstrates the whole unit including the syringe pump, electrical source, and collecting wire.
Figure 1b shows the needle with attached high voltage current and the parallel collecting wires. This study used reduced glutathione and glutaraldehyde with 0.0055 g/mL concentration in PBS and GLU solution in order to produce the GSH solution and immobilization with PCL. Anti-glutathione antibody was used for the detection of GSH attachment with PCL NFM as described below. All chemicals were purchased from Sigma Aldrich. For bacterial analysis, this study used
Staphylococcus aureus bacteria on TSA, TSB medium. Gentamicin (10 mg/mL), PCL, PCL-GSH, PCL-GLU were the sample groups.
2.2. Sample Preparation
This study produced PCL NFM using an electrospun process which was presented in our earlier publication [
16]. In short, PCL beads and acetone were sonicated for 45 min, and then the solution was poured into a 12 mL plastic syringe. A syringe pump ejected the PCL solution through a metallic needle (23 G blunt needle, aluminum make, 25.4 mm length. Model # BX 25). The needle was charged with 9 kV of power. A PCL fiber layer was collected on two parallel wire ground collectors (
Figure 1b and
Figure 2). A 10 mL cell culture plastic pipet was cut about 5 cm height each, and six layers of cross-direction PCL NFM were collected on one of the open ends of the tube through six repeated forward and backward motions (
Figure 2, right image). The fiber was collected roughly at a right angle to the next layer to produce cross-directional PCL NFM.
This study produced three groups of samples (
Figure 3). The collected PCL nanofibers on the tube were soaked with PBS overnight and then sterilized for 2 h under UV light to produce the PCL fibers. The sample was then left to air-dry and subsequently soaked for 48 h with glutathione and glutaraldehyde, or PBS-diluted glutathione solutions to produce two groups of GSH immobilized PCL fiber, referred to as PCL-GSH-PBS and PCL-GSH-GLU, respectively. Glutathione concentration in the GSH-PBS solution for each PCL NFM was 0.0055 g/mL. This value is equivalent to the dosage used daily on mice for our in vivo studies.
2.3. PCL NFM Degradation
The surface morphology of PCL NFM was evaluated with a scanning electron microscope (Hitachi S-4800 Field Emission Scanning Electron Microscope (SEM) with EDS). The fiber mesh surfaces were coated with a thin layer of gold/palladium (Au/Pd) alloy before SEM imaging. The SEM images were obtained with maximal resolution up to 150 eV at an accelerating voltage of 10 kV and magnification up to 10,000×. This study used Image J software to measure the range of fiber diameters (AFD) from the captured SEM images.
Each tube holding the nanofibers was placed in a cell culture well filled with PBS solution where the fiber side of the tube was placed at the bottom of the well. The weight of the tube with fiber was the initial weight,
Wo. Samples were washed daily and placed in a fresh PBS solution. Samples were air-dried and the weight was measured at 10- and 20-day intervals. We air-dried each sample using a mild speed air blower to remove any loose degraded particles and measured the dry weight,
Wd. Each sample was returned to a freshly filled PBS well. The weight loss (degradation) at each time interval was calculated in percentage by the following equations.
2.4. GSH Adhesion and Release Assays
Two assays were conducted to determine: 1. whether GSH could bind to PCL nanofibers; and 2. whether the bound GSH could persist over time. To determine the ability of GSH to adhere to PCL nanofibers, samples were stained using indirect immunofluorescence. Samples were fixed using 4% paraformaldehyde, permeabilized with 0.1% Triton-X-100, then incubated for 1 h at room temperature in rabbit polyclonal anti-glutathione primary antibody (Sigma AB5010, CHEMICON, Darmstadt, Germany 1:100 dilution), washed, then secondarily labeled using goat anti-rabbit Alexa 488 (Invitrogen; Thermo Fisher, Waltham, MA, USA, 1:200 dilution). Samples were mounted with 80% glycerol/PBS and photographed using an Olympus IX-71 fluorescence microscope with DP72 camera and CelSens software (Olympus).
To determine the robustness of GSH attachment, GSH releasing tests were conducted on PCL-GSH-PBS and PCL-GSH-GLU for four-time intervals (1 h, 1 day, 10 days, and 20 days). The fiber sheets from the degradation tests were collected after 1 h, 1 day, 10 days, and 20 days for the glutathione detection with different groups of nanofiber meshes. Additionally, the supernatants from the degradation tests were collected after 1 h, 1 day, 10 days, and 20 days for the GSH release test. These days were selected to determine initial GSH release and based on the same time intervals used in the in vivo study [
17] to examine whether there was a release of GSH in PBS solution for 10 and 20 days intervals. This study followed the instructions of the (Invitrogen) Glutathione Colorimetric Detection Kit (cat.no. EIAGSHC) to measure the amount of GSH released from the supernatants.
2.5. Cell Proliferation Assay
For all experiments requiring cell culture, rat fibroblasts were cultured in a 5% CO2 incubator at 37 °C, in media composed of DMEM (GIBCO/Invitrogen) + 5% fetal bovine serum. Single layers of aligned uni-directional PCL, PCL-GSH-PBS, and PCL-GSH-GLU nanofibers were incubated for 24 h with fibroblasts in media to measure the cell proliferation. Proliferation was studied using a label-ready ethynyl deoxyuridine (EdU) nucleotide followed by click chemistry using a kit (Click-iT; Invitrogen, Thermo Fisher, Waltham, MA, USA) as per manufacturer’s instructions. Pre-cultured fibroblasts were mixed with medium and then seeded in a 96-well plate at 1 × 103 cells per well, then left for two days to incubate. On the second day, EdU diluted in a half volume of fresh media was added to each well at a final concentration of 10 micromolar. Cells were incubated in culture conditions for 24 h in the presence of EdU so that proliferating cells could incorporate it into replicating DNA. After continued incubation for 24 h, the cells were fixed with 4% paraformaldehyde for 20 min. After 3 PBS washes, 0.05 M of Tris buffer was added to the samples and left for 30 min to quench residual aldehydes. Click-chemistry staining of the EdU nucleotide was conducted for 30 min, followed by washes and mounting in 80% glycerol/PBS. Images were obtained using an Olympus IX-71 inverted fluorescent microscope using an Olympus DP72 camera, and captured using CelSens software (Olympus).
2.6. Cell MTT Assay
Cells were plated onto the samples including control (cells in media without treatments) and left in the incubator for 2 days. On the second day, the Vybrant MTT Cell Proliferation Assay Kit (Thermo Fisher, Waltham, MA, USA) was used to conduct MTT assay. The assay measures a cell’s ability to metabolize MTT, which is linearly correlated to cell number. 12 mM MTT stock solution was made by mixing 1 mL of PBS into the vial labeled (MTT 3-(4,5-dimethylthiazol-2-yl)-2,5-diphenyltetrazolium bromide, component A) that was provided by the kit. 10 mL of Acetic acid was added into a tube containing SDS sodium dodecyl sulfate (component B) to completely dissolve the SDS powder. Once the solutions were made, media was completely aspirated from the samples and replaced with 100 microliters of fresh media. 10 microliters of component A were added into each well and left to incubate for 4 h. After 4 h, 100 microliters of component B were added to each well and mixed thoroughly using a pipette (10 microliters of the MTT stock solution for the negative control was also added to 100 microliters of medium alone). This was left for an additional 4 h in the incubator. The samples were then mixed and placed in a microplate reader (BioTek Synergy H1; Agilent Technologies, Santa Clara, CA, USA) and read at an absorbance of 540 nm. The results were then tabulated and made into graphs.
2.7. LDH Cytotoxicity Assay
A cytotoxicity test was conducted on the cells cultured overnight in the three tested conditions following the protocol of the CyQUANT™ LDH Cytotoxicity Assay Kit (C20301) used as directed. The kit measured lactate dehydrogenase released from the cells into the media surrounding cells, which is an indicator of cellular cytotoxicity. To determine the effectiveness of the assay to measure a positive response, 1X LDH Positive Control was made by diluting 1.5 µL of LDH Positive Control with 1 mL of 1% BSA in PBS. One batch of serial dilutions was lysed and used to measure the Maximum LDH Release. The second round of serial dilutions was used to determine the Spontaneous LDH release. The cells were then incubated in a 37 °C incubator overnight. To the Spontaneous LDH Release dilution series of triplicate wells containing cells, 10 µL of sterile water was added. The Maximum LDH Release dilution series was increased by 10 µL of 10X Lysis buffer. After 45 min in an incubator at 37 °C, 50 µL of each sample medium was transferred to a 96-well flat-bottom plate in triplicate wells. Each sample’s wells received 50 µL of Reaction Mixture. After incubating the plate for 30 min, 50 µL of Stop Solution was added to each sample well. Within 1 to 2 h of adding Stop Solution, the absorbance was measured at 490 and 680 nanometers. The absorbance value from 680 nm was subtracted from the 490 nm absorbance value to determine the LDH activity.
2.8. Antibacterial Analysis
PCL disks were exposed to UV light about 3 to 6 h prior to sample preparation. PCL-GSH-GLU and PCL-GSH-PBS were prepared a day before the experiment. PCL-GLU discs were prepared alongside the other sample groups to ensure the activity of GLU. PCL mesh circles were formed using a 9 mm puncher followed by placing 10 µL gentamicin on one PCL disc. The spreader was sterilized with ethanol and flaming sterilization. 100 µL of Staphylococcus aureus (ATCC 25923) was spread evenly throughout the tryptic soy agar plate. Discs (treated sample groups, positive control-gentamicin and negative control PCL) were gently placed on the agar plate containing the bacteria under aseptic conditions. After 20 h of incubation at 37 °C, antibacterial activity was evaluated by measuring the diameter of the clear zone; the average diameter of the inhibition zone surrounding the disk was measured with the help of a ruler. The mean reported for each sample group was based on three replicates.
2.9. Statistical Analysis
The KaleidaGraph software statistical analysis tool was used to differentiate factors (group) in the study parameters [
15]. Independent sample
t-tests were used to test for differences in mean cell proliferation and adhesion, degradation and releasing, cytotoxcicity, MTT assay, bacterial analysis and the variation between the control and treated samples. Differences between the two groups were determined one-way ANOVA with values of
p < 0.05 considered statistically significant.
4. Discussion
ROS are emerging as substances that cause several degenerative diseases such as diabetes [
18]. ROS exists in various molecular forms such as H
2O
2, ions such as ClO-, superoxide anions, and free radicals such as ·OH. Superoxide anions in the body are produced during direct oxygen reduction when electrons leak from the electron transfer chain and oxidative phosphorylation processes in mitochondria [
19]. Since very unstable superoxide anions are converted to the more stable H
2O
2 by superoxide dismutase, most of the ROS observed in the body takes the form of H
2O
2. Most H
2O
2 is converted to non-toxic H
2O by antioxidants such as catalase and peroxidase in cells [
20]. As described above, mitochondria are places where ROS are mainly produced, and the genome of mitochondria is vulnerable to oxidative damage and mutations caused by free radicals [
21]. This is because the production of free radicals occurs nearby, and due to the nature of mtDNA, there are no histone proteins to protect and there is proofreading deficiency in mitochondrial DNA polymerase [
22,
23]. In particular, when fat accumulates in the body, overall oxidative stress increases due to an increase in NADPH oxidase, an enzyme that produces ROS in adipose cells, and a decrease in antioxidants [
24]. These oxidative stresses cause various diabetes complications. In our earlier study, we found that the high levels of sugar in diabetic male mice were significantly decreased due to the daily injection of glutathione. Moreover, oxidative stress in diabetic male mice leads to depletion of total glutathione levels in body organs (pancreas, spleen, epididymis, and testis). Continuous exposure to antioxidants has been suggested as a treatment for alleviating diabetes complications and preventing diabetes from progressing [
25]. We developed a nanofiber NFM containing drugs as a drug delivery method in this experiment.
GSH is an antioxidant found in animals, plants, and fungi which can be used as a substance that effectively neutralizes ROSs that have increased due to diabetes. GSH is a tripeptide protein that consists of three amino acids; glycine, glutamate, and cysteine [
26]. The thiol group in cysteine reduces ROS, glutamate acts as an excitatory neurotransmitter, and glycine acts as an inhibitory neurotransmitter in the central nervous system. GSH makes oxidized vitamin C into reduced vitamin C that can pass through red blood cells and the blood-brain barrier (BBB). Vitamin C, upon entering red blood cells or BBB, is reduced again with the help of glutathione and is involved in the production and regulation of various neurotransmitters and hormones. In other words, GSH is the helper needed for vitamin C to work as a powerful antioxidant. GSH is synthesized 70% in the liver, 15% in the kidneys, and 15% in the lungs to protect all cells, tissues, and organs from ROS and diseases and to play a role in keeping the antioxidant network constant in the body [
27]. In addition, GSH is a good anti-inflammatory substance by strengthening interleukin-1, which acts as an anti-inflammatory agent, and interleukin-2, which promotes immune cell differentiation and growth [
25,
28]. GLU is a disinfectant approved by the Centers for Disease Control and Prevention (CDC) mainly used to sterilize medical devices in hospitals and has sterilization and disinfection effects [
29]. GLU deprotonates amines on the cell surface, therefore the structure of proteins is disrupted [
30]. GSH is a water-soluble compound and GLU is a polar liquid, and miscible to water [
26]. GLU has an antibacterial effect and not only acts as a good solvent to GSH but also shows better cell viability when the GSH-GLU combination is used.
Recent findings suggest the possibility of a new transdermal anti-oxidative drug delivery method based on the slow degrading rate of PCL. Several studies have been conducted for similar antibacterial purposes of releasing GLU using other polymer materials like polyurethane, yet the activity of glutaraldehyde was not sustained over long periods of time [
31]. The property of PCL as being a synthetic biodegradable and bioresorbable polymer to be a proper biocompatible product, allows us to get benefit in several biomedical applications that have been approved by the FDA. PCL is a member of the aliphatic polyester family of compounds, whereby increasing the molecular weight its crystallinity would decrease. In addition, PCL has high crystallinity and hydrophobicity which makes this polymer degrade at a slow rate [
32]. Based on our findings, no degradation on any sample group was seen after 10 days of incubation, but instead, the sample group demonstrated gaining weight. The degradation test showed increased weight in both GSH samples relative to PCL (control). This means that the hydrophilic characteristics of PCL can be improved by attaching GSH with PCL using GSH-PBS and GSH-GLU solutions. These results also suggested that the GSH attached with the PCL surface and increased the matrix weight. Most importantly, the structural integrity of the fiber matrix was intact due to the GSH immobilization for up to 20 days. This also suggests that immobilizing GSH with PCL using glutaraldehyde solution, instead of PBS solution, stops the release of GSH from the nanofibers. This study also proposed that PCL-GSH-GLU samples could release GSH at a steady rate until the degradation of fiber. Since this study was limited to a 20 days’ time interval and there was no observed degradation within 20 days, we are unable to test this proposition. Furthermore, this study found that when we immobilize the glutathione onto the PCL using PBS or GLU, glutathione was stuck to the PCL surface and immobilized evenly throughout the whole surface of the nanofibers (
Figure 5).
Fibroblasts’ ability to attach, metabolize and proliferate were demonstrated in two separate assays, EdU-click and MTT assays. MTT assay results showed the quantitative difference of cell attachment among the sample groups (
Figure 8). While the average values of fibroblast metabolic activity in PCL and GSH immobilized PCL samples were lower than control, the differences were not statistically significant. The difference of O.D values between PCL and GSH-immobilized PCL surfaces was also insignificant. These findings indicate that the GSH-immobilized PCL nanofibers did not exert additional effects on cellular metabolism, and indirectly suggest adhesion was unaffected. Cells survived, adhered to, and proliferated on the PCL and GSH-immobilized PCL surfaces (
Figure 7). A previous study [
33] demonstrated when cells successfully bind to PCL they subsequently secrete extracellular matrix (ECM) to keep their surroundings suitable for growth. This cellular metabolic activity was slightly different from control (cells only in the well), where cells were homogeneously distributed around the well. Cell attachment similar to control can be achieved by using cross or random directions on multiple layers of fiber which was observed in our earlier study using mouse osteoblast cells [
16].
The uniqueness of this study proposed that the dermal equivalent model -PCL collagen based [
34] provides a suitable condition to have antibacterial properties as well as drug-releasing (GSH) properties. According to the degradation test, it was not showing any degradation after 10 days in any treated samples. However, the increase in weight was noticed in sample groups and that suggested PCL absorbed GSH and GLU. According to
Table 1, there was a weight increase between PCL-PBS 0.19 and two other sample groups, PCL-GSH-PBS and PCL-GSH-GLU, of 0.54 and 0.50, respectively, after 10 days. This would confirm that GSH was absorbed into the PCL. On the other hand, based on the releasing test results, PCL-GSH-PBS and PCL-GSH-GLU both confirmed the release of GSH. The release of GSH in PCL-GSH-GLU was steady and gradually in which, referring to
Table 1, the weight differences between these two sample groups with day 10 and 20 support this manner.
One appropriate indicator of cytotoxicity is release of cytosolic LDH through a damaged plasma membrane. LDH is a cytosolic enzyme that is present in many cells. The released LDH enters the cell culture medium and its enzymatic activity is measured; the activity is dependent on cell number. This suggests higher cell concentrations would demonstrate higher cytotoxicity. The obtained results highly demonstrated the low cell concentration or low toxicity of the treated sample groups compared to the control group. Yet among the sample groups, PCL-GSH-GLU demonstrated the lowest absorbance and cell concentration which, combined, demonstrated least toxicity (
Figure 9). PCL and PCL-GSH-PBS groups show the next higher toxication respectively.
Antibacterial analysis revealed that GLU has antibacterial properties while GSH did not show any inhibition zone. According to
Table 2, PCL-GLU shows the average of 12.7 mm inhibition zone and 13 mm for PCL-GSH-GLU respectively. This indicates that GLU itself has antibacterial properties and combining that with GSH demonstrated larger inhibition zones and ultimately stronger antibacterial products. The lack of a clear zone using PCL-GSH-PBS treatment (
Figure 10c) suggests that GSH itself does not have the characteristics as an antibacterial drug.
Our finding suggests the application of GSH-GLU with the PCL fiber to increase the capability of anti-inflammatory and antibacterial properties of the product to be used in several biomedical applications. However, it requires further study to expand the knowledge and findings to better understand the characteristics of GLU and GSH combined with PCL by conducting genome-based tests that include several methods to be able to characterize the bacterial activity interacting with these drugs. In addition, future work will be conducted with larger sample groups for better accuracy in results.
The translation of this study is to develop the skin equivalent model to add GSH combining with GLU and PBS to see the effect whether it has the antibacterial and drug releasing properties. In our previous study we already developed a collagen PCL based skin equivalent model [
34]. In that research study we found that PCL collagen is a suitable model for skin equivalent. In this paper we tried to add GSH with different solvent of GLU and PBS to see the outcome of the skin model in order to find a suitable model for diabetic patients. As part of our limitation in this study, we considered the in vitro study over the treated skin equivalent model. In our separate ongoing research, we are currently doing animal study with the PCL collagen based skin model which the result is going to publish in a separate paper.